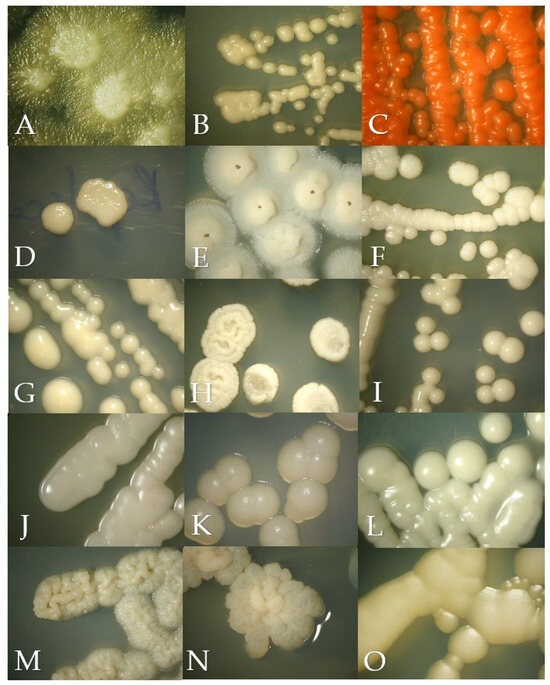
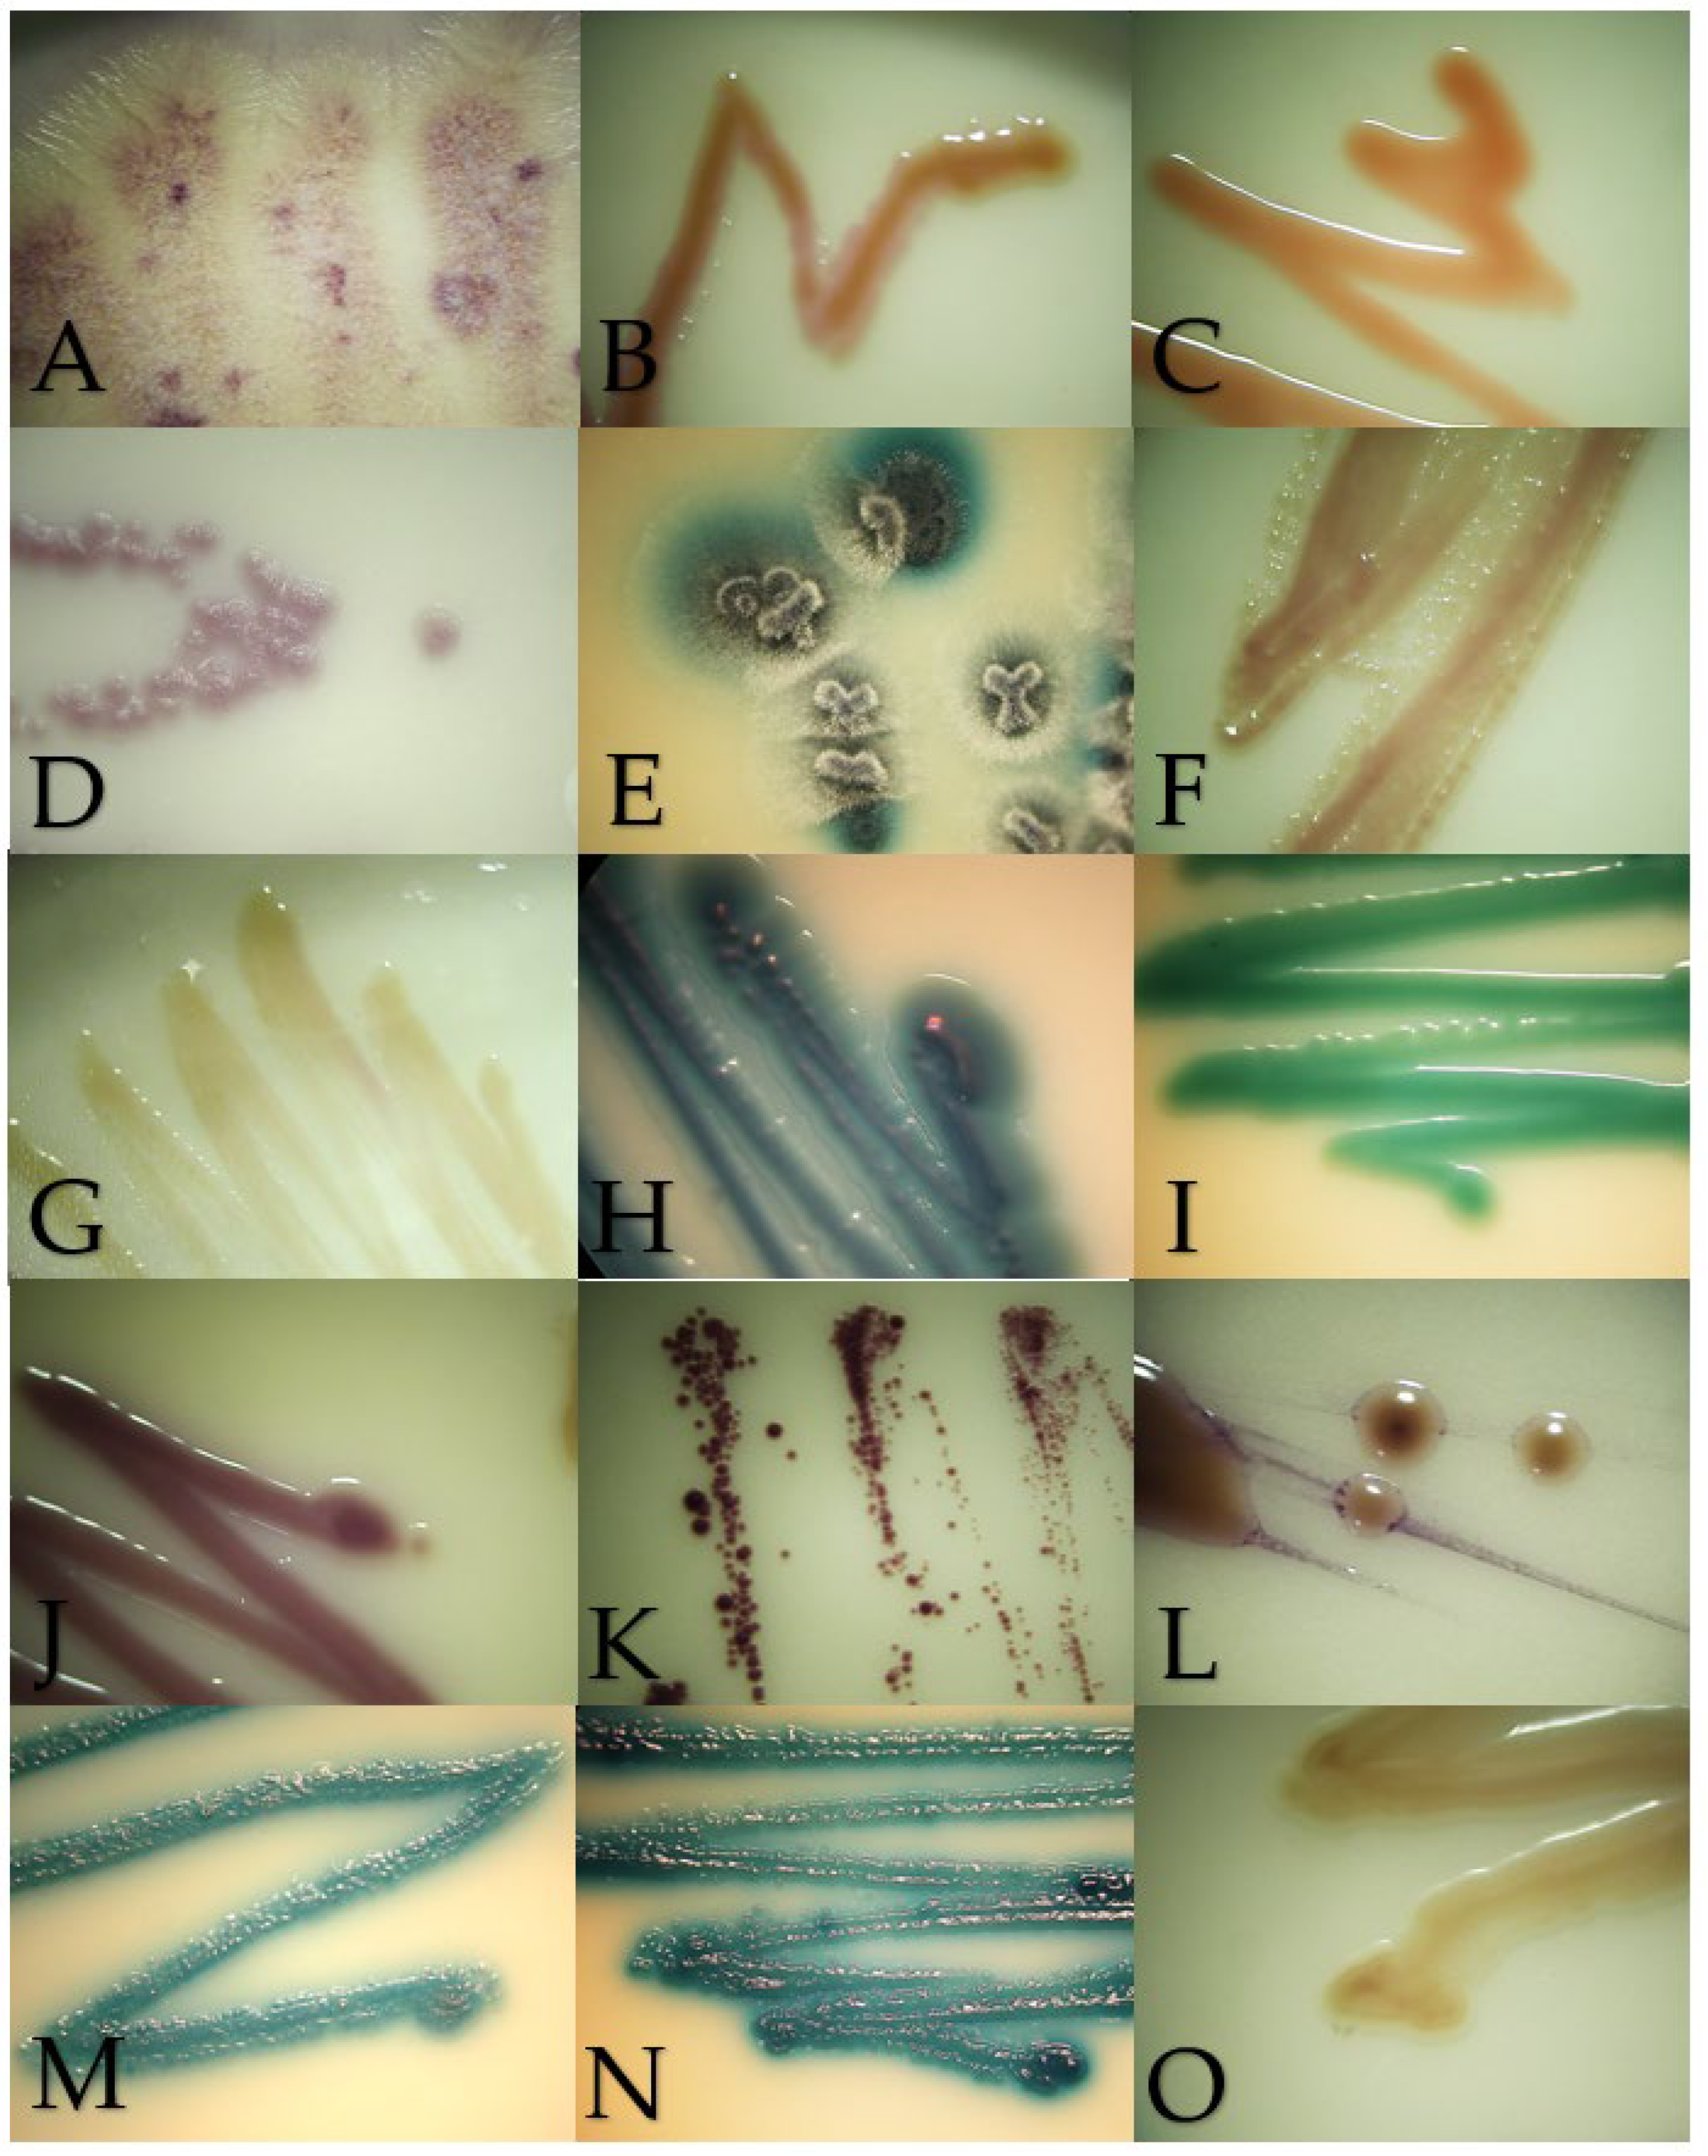
Jof 10 00218 g002

Abstract
Yeast infections are challenging human and animal medicine due to low rates of detection and the emergence of unknown ecology isolates. The aim of this study was to verify the biochemical identification of yeasts and yeast-like microorganisms obtained from animals comparing the results with chromogenic media and matrix-assisted laser desorption/ionization time-of-flight (MALDI-TOF MS). Between January and August 2023, yeast and yeast-like isolates from samples of animals with suspicion of mycosis were identified using Vitek® 2 Compact, Brilliance® Candida Agar and MALDI Biotyper® MSP. A total of 39 cases were included, and 45 isolations were obtained. Cryptococcus neoformans (15.5%, 7/45), Meyerozyma guilliermondii (13.3%, 6/45), Candida parapsilosis (11.1%, 5/45), Candida albicans and Candida tropicalis (8.9%, each one 4/45) were the most identified organisms. There was full agreement with the three identification methods in 71.1% (32/45) of the isolates, disagreement on species in 17.8% (8/45), disagreement on genus and species in 6.7% (3/45) and, in 4.4% (2/45), there was no matched pattern in MALDI-TOF to compare the results. Biochemical methods are a good option in laboratories where proteomics are not available, and chromogenic media enhances diagnostics by detecting mixed infections. Surveillance must be implemented to improve the detection of agents shared between humans and animals.
1. Introduction
Mycoses caused by yeasts are a growing challenge in human medicine, particularly in patients with immunosuppression, hospitalized, transplanted, carriers of medical devices or central catheters and with chronic diseases such as diabetes, mainly because its detection is less than 50% in cases of invasive mycoses or fungemia [1,2]. During the period of 2010–2019, reports on yeast infections doubled the publications available in the decade of 1990–1999 (50,000 reports against 25,000) but continues to be less inferior than bacterial articles (350,000) [3]. Yeasts infections are mostly caused by species of the genus Candida but also by emerging pathogens. The management of emerging pathogens are more difficult, because the ecology and pathogenicity are unknown, and if intrinsic antifungal resistance exists, then evidence-based treatment cannot be performed as expected, and failure can occur [1,4].
Regarding animals, yeast infections are rarely reported, except for those caused by the genera Malassezia, Candida and Cryptococcus, which cause otitis and dermatitis; subcutaneous masses or gastrointestinal, respiratory and central nervous system compromises [5,6,7,8]. The diagnosis of yeasts represents a challenge in veterinary medicine, since animals have closer contact with the environment and it is possible to find transitory or pathogenic environmental microorganisms in them [6,9,10]. These yeasts are usually identified by commercial biochemical assays designed to detect the most common human pathogens, so the databases are very limited, and the identification is given at the genus level, and to attempt the species, molecular identification must be performed [4,11]. As molecular methods are expensive, most times, they are not pursued by the guardians of the animals, and consequently, the identification is not carried out or is carried out later for research purposes.
To support the morphological and biochemical results, chromogenic culture media are a good resource to detect multiple agents in the primary culture to give a preliminary characterization of the isolates and to confirm the purity of a strain. Those kinds of media use chromogenic substrates, which, in the presence of certain enzymes, result in the formation of colonies of a particular color: blue (Candida tropicalis), green (Candida albicans and Candida dubliniensis), pink (Pichia kudriavzevii, formerly Candida krusei) and beige or brown (other yeasts) [12,13,14]. Nevertheless, interpreting the results is dependent on the brand of the media and the available images to compare the spectra of colors of the isolates that are available only for the most frequent agents on the web or in research papers [12,13,14].
An alternative for yeast identification (in centers where it is available) is matrix-assisted laser desorption/ionization time-of-flight mass spectrometry (MALDI-TOF MS). This is a simple, fast, specific technique that can identify several genera and species [15]. This proteomic system generates a spectrum of the proteins of the microorganism, which is then compared to those found in the database of the equipment used, thus obtaining identification. However, to obtain better results, the database must be enhanced with local isolates from multiple samples [16].
This research was carried out with the objective of verifying the identification of yeast and yeast-like microorganisms isolated from animals by comparing the results of a biochemical semi-automated method (Vitek® 2 Compact) with a chromogenic media (Brilliance® Candida Agar) and mass spectrophotometry (MALDI Biotyper® MSP).
2. Materials and Methods
During January to August 2023, a survey on the identification of yeast and yeast-like isolates obtained from clinical samples of domestic and wild animals with suspicion of superficial and deep mycosis was made at the Mycology Laboratory of Universidad Nacional, Heredia, Costa Rica. Isolates stored in the laboratory collection and those obtained during the period were considered.
The samples were cultured by the streak method (in the case of swabs and liquids) or by small portions (in the case of biopsies and scrapings) on Sabouraud Dextrose agar (SDA) (Oxoid Ltd., Basingstoke, Hants, UK) and incubated at 28 °C and 37 °C for one week, apart from skin scrapings where it grew for two weeks and biopsies for three weeks. When it was available, primary cultures on Brilliance® Candida Agar (BCA) (Oxoid Ltd., Basingstoke, Hants, UK) were made to detect mixed cultures.
Significant growth was considered when (1) colonies appeared over the inoculated sample in the case of biopsies and scrapings in at least one zone of growth using the streak method and when it was in the presence of encapsulated, budding or phagocytized yeasts or hyphae and pseudomycelia in the direct examination (Gram and/or Giemsa stains); (2) when the isolation came from a sterile organ; (3) when it was a culture of treatment monitoring of a previous diagnosed disease and (4) when it was a isolate submitted for identification from a private veterinary diagnostic laboratory.
Transitory growth was annotated when no fungal elements were seen in the direct examination. The significance of growth was not determined in the cases where no direct examination was made to classify it as significant or transitory. To confirm the purity and corroborate the microscopic morphology of the colonies, Gram staining was performed on each isolate. Gram staining was chosen to detect and classify the bacterial contamination of the isolates. Subcultures on BCA and SDA incubated at 28 °C for 24, 48 and 72 h were done to evaluate the macroscopic appearance. As a control for BCA growth and color development, the strains Issatchenkia orientalis derived from ATCC® 6258, Candida albicans derived from ATCC® 14053 and Candida parapsilosis derived from ATCC® 22019 were used.
2.1. Biochemical Identification
Biochemical identification was made with Vitek® 2 Compact (bioMérieux, Inc., Durham, NC, USA) using the yeast identification cards (YST), which allow the identification of fungi and fungal-like algae of the genera Candida, Cryptococcus, Malassezia, Prototheca, Rhodotorula and Trichosporon and the species Geotrichum klebahnii. To carry out the identification of the microorganisms, pure cultures on SDA after 24 h of growth were used (except for isolates of Malassezia, Prototheca, Trichosporon, Cryptococcus and Geotrichum, which were left up to 72 h). The incubation was in an aerobic atmosphere at a temperature of 28 °C, except Malassezia and Prototheca at 37 °C. The stored isolates were subcultured twice before this procedure. Solutions of the microorganisms were prepared in a sterile saline solution with a volume between 1.8 and 2.2 McFarland and reeded with Densichek (bioMérieux, Inc., Durham, NC, USA). Then, the recommendations of the commercial house were followed to handle samples using the equipment, and their interpretation was as follows: an excellent identification was considered if the probability was 96 to 99%, very good if the probability was 93 to 95%, good if the probability was 89 to 92% and, finally, it was an acceptable identification if the probability was between 85 and 88%.
2.2. Proteomic MALDI-TOF Identification
Proteomic identification by mass spectrophotometry with MALDI-TOF was performed using the MALDI Biotyper® MSP (Bruker Daltonics GmBH & Co. KG, Bremen, Germany) from the Mycology Reference Laboratory of the Costa Rican Institute for Research and Teaching in Nutrition and Health (INCIENSA) to corroborate the biochemical identification. For this technique, cultures on SDA for 24 to 72 h incubated between 30 and 37 °C were used. A minimum amount of the colony of interest of the microorganism was placed with the help of a wooden stick on the 96-well metal plate, then 1 µL of 70% formic acid was added. It was allowed to dry, and 1 µL of the matrix was used. Once the plate was ready, the reading was carried out. Each sample was processed in duplicate, and Escherichia coli isolation was used as a calibrator and as a control. The identification at the species level was given if the first ten identities were the same microorganism and if at least the first three had scores above 1.75 [15].
2.3. Results Interpretation and Data Register
Macroscopic morphology in SDA and the microscopic appearance in Gram staining was compared to the clades given in reference literature [17,18]. The results of the BCA were analyzed following the prospect of the product and research papers [12,13,14]. When controversial results were obtained, the color of the colony in BCA was revised to support one of the results, and when no reference of the color was available, MALDI-TOF results were preferred over Vitek’s, because the nomenclature is actualized, the profile of proteins is more specific than biochemical reactions that are shared by multiple yeasts and MALDI-TOF can differentiate species from complex species.
The data were registered in Microsoft® Excel® (Microsoft 365 MSO, version 2401, 64 bits) sheets including the following information: laboratory identification; animal source; type of sample; microscopic direct examination results; classification of the growth (significant, transitory or significance not determined, as explained above); type of isolate (pure or mixed); photographs of the macroscopic morphology in SDA and BCA and of the microscopic morphology in Gram staining, Vitek® 2 Compact identification with their percentage of probability and MALDI Biotyper® MSP identification with their corresponding score.
3. Results
A total of 39 cases from 28 domestic and 11 wild animals were included in the study. Most of the cases were dogs 30.8% (12/39), followed by cats 28.2% (11/39), two-toed sloths (Choloepus hoffmanni) 12.9% (5/39) and mares 10.3% (4/39). The cases involved isolates from multiple samples, such as skin scrapings; swabs of the oral cavity and ear canal, esophagus and crop; uterine lavages and skin, lung, kidney, lymph node and colon biopsies, among others. Most of the cultures were 89.7% pure (35/39), and mixed cultures were also detected 10.3% (4/39). Significant growth was seen in 69.2% of the cases (27/39). Meanwhile, a quarter (25.7%) of the cultures were classified as transitory (10/39), and in two cases, it was not possible to determine the significance, as no microscopic direct examination was made (5.1%) (Table 1).

Table 1.
Animal source and type of samples and classification of the cultures included in the study.
From those cases, 45 yeast and yeast-like isolates were obtained. The more frequent were Cryptococcus neoformans (15.5%, 7/45), Meyerozyma guilliermondii (13.3%, 6/45), Candida parapsilosis (11.1%, 5/45), Candida albicans and Candida tropicalis (8.9%, each one 4/45). There was full agreement with the three identification methods in 71.1% (32/45) of the isolates, partial agreement on the genus but different species in 17.8% (8/45), disagreement on the genus and species in 6.7% (3/45) and, in 4.4% (2/45), there was no matched pattern in the MALDI-TOF to compare with the Vitek® 2 Compact results (Table 2).

Table 2.
Results of the identification of the isolates by Brilliance® Candida, Vitek® 2 Compact and MALDI-TOF Biotyper® MSP.
All the isolates of C. albicans (4/4), C. neoformans (7/7), N. glabrata (2/2) and M. pachydermatis (2/2) had the same result in the biochemical and in the proteomic assays and their expected color in the chromogenic media. On the other hand, M. guilliermondii and C. parapsilosis were also well identified by both methods (5/6 and 5/5, respectively); however, MALDI-TOF could identify one Candida orthopsilosis, which Vitek identified as C. parapsilosis, and a misidentification of one M. guilliermondii as Candida ciferri occurred with Vitek. Despite that MALDI-TOF gave the spectra for Prototheca zopfii and Prototheca wickerhamii, both were identified only by Vitek, because those microorganisms were not in the database of MALDI-TOF (Table 2).
All the isolates of C. neoformans were from cats and significant (7/7); the majority of M. guilliermondii were transitory isolations from skin (5/6), and the other microorganisms were from distinct organs and animals classified as significant or transitory agents (Table 3).

Table 3.
Distribution of the isolates according to animal source, sampled organ and significance.
The macroscopic morphology of the isolates on SDA were creamy colonies with a smooth or rough texture white, cream or fuchsia in color (Figure 1). Regarding the growth in BCA, the isolates ranged from cream, beige, orange, blue, green to purple colors (Figure 2). The microscopic morphology of the yeasts varied with respect to the identified genus, with round to oval multiple- or single-budding yeasts observed and the presence of hyphae and pseudohyphae (Figure 3). A detailed description of the isolates is given in Appendix A.
Figure 1.
Macroscopic morphology of the isolates in Sabouraud Dextrose Agar after 24 to 72 h of incubation at 28 °C, except for Malassezia pachydermatis incubated at 37 °C. (A) Geotrichum candidum, (B) Cryptococcus neoformans, (C) Rhodotorula mucilaginosa, (D) Prototheca zopfii, (E) Trichosporon asahii, (F) Candida parapsilosis, (G) Nakaseomyces glabrata, (H) Candida tropicalis, (I) Candida albicans, (J) Meyerozyma guilliermondii, (K) Malassezia pachydermatis, (L) Papiliotrema laurentii, (M) Cutaneotrichosporon jirovecii, (N) Trichosporon coremiiforme and (O) Debaryomyces nepalensis.

Figure 2.
Macroscopic morphology of the isolates in Brilliance Candida Agar after 48–72 h of incubation at 28 °C, except for Malassezia pachydermatis incubated at 37 °C. (A) Geotrichum candidum, (B) Cryptococcus neoformans, (C) Rhodotorula mucilaginosa, (D) Prototheca zopfii, (E) Trichosporon asahii, (F) Candida parapsilosis, (G) Nakaseomyces glabrata, (H) Candida tropicalis, (I) Candida albicans, (J) Meyerozyma guilliermondii, (K) Malassezia pachydermatis, (L) Papiliotrema laurentii, (M) Cutaneotrichosporon jirovecii, (N) Trichosporon coremiiforme and (O) Debaryomyces nepalensis.

Figure 3.
Microscopic morphology of the isolates by Gram staining in 1000× immersion oil. Scale bar 10.33 µm. (A) Geotrichum candidum, (B) Cryptococcus neoformans, (C) Rhodotorula mucilaginosa, (D) Prototheca zopfii, (E) Trichosporon asahii, (F) Candida parapsilosis, (G) Nakaseomyces glabrata, (H) Candida tropicalis, (I) Candida albicans, (J) Meyerozyma guilliermondii, (K) Malassezia pachydermatis, (L) Papiliotrema laurentii, (M) Cutaneotrichosporon jirovecii, (N) Trichosporon coremiiforme and (O) Debaryomyces nepalensis.
4. Discussion
Forty-five yeast and yeast-like microorganisms isolated from animals with signs of superficial and deep or systemic mycoses were identified in this study. Well-known medically important fungi such as C. neoformans, C. parapsilosis, C. albicans and C. tropicalis were frequently involved in the cases. Meanwhile, others less common but increasingly more so agents of infections, such as M. guilliermondii, R. mucilaginosa, P. laurentii and G. candidum, were also detected with significant or transitory participation, as well as fungi scarcely reported, such as T. coremiiforme, C. jirovecii and D. nepalensis and fungal-like achlorophyllous algae Prototheca zopfii and Prototheca wickerhamii [17,18,19].
Four agents detected here are included in the Fungal Priority Pathogens List of the World Health Organization (2022): C. neoformans, from the critical priority group and N. glabrata, C. parapsilosis and C. tropicalis from the high priority group [2]. The latter classification was made “to guide research, development and public health action”, focused on the listed fungi, and those pathogens were prioritized based on the capacity to cause invasive and systemic mycoses for which treatment and management challenges exist, as well as drug resistance, considering that, in Costa Rica, there are also few reports on yeast infections in humans, the majority retrospective studies of candidemia and cryptococcosis. Regarding candidemia, INCIENSA has the records from the period 2018–2021 of the blood cultures from the main hospitals, with C. albicans, C. parapsilosis, C. tropicalis and N. glabrata (in that order) the most frequently identified [20]. However, in the two largest hospitals of this country (Hospital San Juan de Dios and Hospital México), the order of the fungal pathogens varies between places and periods [21,22,23]. In reference to cryptococcosis, this disease is prevalent in the country, mainly in patients with Human Immunodeficiency Virus (HIV) (72.7%) but also in immunocompetent patients (20%) and the rest by drug-mediated immunodeficiencies [24]. All these fungal pathogens are transmitted by exposure to the environment or by nosocomial and medical devices contamination, which reinforces the necessity of collaboration between human and animal diagnoses to detect mutual sanitary threats.
Cryptococcus neoformans, the most frequently identified agent here (15.5%, 7/45), were only detected in cats, and in all the cases, its role was considered significant (Table 3). The affected organs included the nose, skin, lymph nodes and bladder, which is consistent with what has been reported in this animal: mycotic rhinitis with colonization of the nasal cavity, single or multiple skin lesions and lymph nodes enlargement are the main clinical presentation of cryptococcosis [5,25,26]. Due to the behavior of burying feces and hunting, cats are exposed to acquiring fungal agents from the environment, which can cause disease or remain on their surfaces as asymptomatic carriers, which is why, in the case of sapronosis (fungal infections acquired from the environment), they are good bioindicators of contaminated environments [27] and can indicate a common source of exposure for the people they live with. Cryptococcosis is the most common systemic fungal disease in domestic felines and manifests mainly as an inflammation of the nasal mucosa that may or may not spread to the lower respiratory tract and cause lymphadenopathy or infection of the central nervous system [27]. Contrary to what happens in humans, in which the disease caused by C. neoformans manifests mainly in immunosuppressed patients [18], in cats, it has been seen that this disease is also contracted by animals in which immunosuppression was not detected [27], opening up the possibility that a large inoculum from the environment can promote the development of signs.
Surprisingly, M. guilliermondii was the second-most isolated species (13.3%, 6/45), but its participation was classified as transitory from the skin in almost all the cultures (83.3%, 5/6) and, in only one case of a two-toed sloth (Choloepus hoffmanni) (INV-002-23), was considered significant. This fungus is an emerging cause of invasive infections in humans, and in animals, this yeast has been associated with integumentary and genitourinary tract infections in dogs and cats, alimentary tract infections in poultry, abortion and mastitis in cattle and fungal keratitis and abortion in horses [5,25,28] and has also been detected as a commensal of oropharynx and cloaca of rheas (Rhea americana) [29] and in the nasolacrimal duct in horses [30].
Candida parapsilosis is part of a complex with C. orthopsilosis and C. metapsilosis, which causes multiple infections in humans but is more relevant as causing endocarditis, and by its elevated minimal inhibitory concentrations (MICs) for echinocandins [17,18]. In animals, this complex causes the same clinics as M. guilliermondii [5]. Two species of this complex were identified in this study: C. parapsilosis sensu stricto was the third-most common agent (11.1%, 5/45), isolated mainly from superficial samples (80%, 4/5) from dogs and cats, but its detection was highlighted in a sample of prostate aspirate from a dog and in the ear canal from a bat. On the other hand, C. orthopsilosis was identified by proteomic from a uterine infection in a mare, and without MALDI, this species could not be determined.
Following with the cases of uterine infections in mares from this survey, apart from the mentioned isolation of C. orthopsilosis, 66.6% (2/3) were associated with C. tropicalis. Those findings are important for three reasons: (1) fungal endometritis in horses is rare, representing 1–5% of the reported cases [31]; (2) in a robust retrospective study of a 13-year period on equine uterine fungal isolates, yeasts were the most common fungal agents (69%, 70/102), but no information about the genera and species were given [32]; and (3) in a study with 453 samples from the reproductive tract of healthy mares, no isolates from those two agents were found, despite Candida spp. being the most frequent genus isolated (53.2%), suggesting they are not part of the normal microbiota [33].
Geotrichum candidum were also identified in a mare but in the skin, and the finding was considered significant. Even though it is a saprophytic fungus, it is not commonly isolated from the skin and hair of normal horses, and it has been associated with an extremely rare dermatitis in horses in Brazil, causing areas of alopecia and producing scaling lesions [34]. Also, a case of fatal diarrhea in a horse with systemic dissemination was also reported in Brazil [35], so veterinarians should be aware of this agent in countries with similar weather to Brazil in case it could be detected on some other occasion.
It is worth mentioning digestive system isolates from dogs in which Trichosporon asahii (66.7%, 2/3) and fungal-like algae P. zopfii (33.3%, 1/3) were detected. The first one is not related to gastrointestinal disorders in animals and, in humans, is considered a contaminant of that kind of samples but an important pathogen found in samples of blood, urine and bronchoalveolar lavages [17,18]. Here, it was considered significant, as phagocytosed and free yeasts were observed in the microscopic direct examination of both colon biopsy samples, and it was isolated as pure. Therefore, further investigation is needed to elucidate the role of this agent in canine colitis, since no similar reports were found. On the other hand, P. zopfii is an expectable agent, since it has been reported in similar cases in Costa Rica [36] but, in other countries, is not a common finding. Prototheca zopfii and Prototheca wickerhamii isolates were not identified by MALDI-TOF, as the genus was not included in the database, and the same situation occurred in research from Belgium with animal isolates [37].
Another important fact is that the two-toed sloth (Choloepus hoffmanii) was the third-most frequent animal (12.9%, 5/39) from which isolates were recovered, the majority being from the digestive system (60%, 3/5), and the involved agents included C. albicans, M. guilliermondii, C. jirovecii and D. nepalensis. Specimens of this herbivorous wild animal, the national symbol of Costa Rica, are commonly encountered in rescue centers by different causes, but gastric complications by stress and diet adaptations are the main complications in captivity [38]. Mycotic glossitis/stomatitis and gastritis have been reported in sloths by histopathology, suggesting candidiasis [39,40,41]; nevertheless, case reports involving identification of the fungi and studies on their mycobiota were not found.
Although reports of yeasts in wild animals are very scarce, their transient isolations in those kind of animals in the present study were not surprising, since, according to a review on the evolution and genetics of yeasts, of the 76 new species described recently, only seven were related to human environments, the other sources being soil, plants, fruits, water and insects, among others [42], and those other sources are more likely to get in touch (by contact or by ingestion) with wild animals than humans. Also, yeast passes the gastrointestinal tract and can be isolated from feces, like in a survey of 325 droppings of parrots in Italy, where 49.2% from those were positive to 27 different species of yeasts, the majority from the genus Candida but also from the genera Debaryomyces, Geotrichum, Pichia and Rhodotorula [43]. Another example is the research on the mycobiome of wild herbivorous mammals (genus Neotoma) in 25 populations in the Southwestern United States, in which fungal assemblages were dominated by plant pathogens and molds, but their compositions varied by the animals’ habitats and significantly decreased in captivity [44]. Therefore, in the cases where the significant isolation of yeasts was detected in this study, it could be attributed to the stress of captivity and antibiotic therapy to which animals are exposed.
Chromogenic media provided benefits to identified mixed cultures, particularly in samples from the digestive system from exotic and wild animals. In this survey, mixed cultures with two or three isolates were detected in an ulcerative skin lesion of a cat (4302-21S), the lung of a Finch’s parakeet (Psittacara finschi) (INV-006-22), the crop of a southern mealy parrot (Amazona farinosa) (INV-009-22) and the oral cavity of a two-toed sloth (Choloepus hoffmanii) (INV-010-22). Also, the results of the BCA helped to identify isolates with controversial results in Vitek. One of the cases was VS-382-22, where the Vitek probability was Candida ciferri (98%) and the MALDI result was M. guilliermondii with a score of 1.88; despite no data on BCA growth for C. ciferri, all the isolates of M. guilliermondii were purple, as well this isolate (Figure 2J). Another controversial case was INV-010-22, where C. tropicalis (91%) was identified by Vitek, and the score for C. jirovecii was 1.92 as the result of MALDI. Both species have similar morphologies in SDA (Figure 3H,M), and by their hexosaminidase activity, both species could have greenish-blue appearance in BCA [12,13] (Figure 2M). Microscopically, they could be differentiated by the presence of arthroconidia in C. jirovecii (Figure 3M), but in this case, molecular identification is needed corroborate the species.
Biochemical identification by the Vitek® 2 System was a good method to identify yeasts from animal origins, especially when the isolate came from a domestic animal and C. albicans, C. neoformans and N. glabrata were suspected, since, in the present research, all the isolates from those species had excellent, very good and good probability with this biochemical method, and MALDI-TOF corroborated their identity with scores higher than 1.7.
MALDI-TOF is routinely used in the diagnosis and research of pathogens in humans [45], but with veterinary isolates, it has been more focused on isolates from foods of animal origins [46] or detecting contaminants from animal excreta [47] and for research purposes [37] rather than for diagnosis. In this research, MALDI-TOF was a fair method to correct species with similar biochemical profiles given by Vitek, like C. ciferii vs. M. gulliermondii, G. klebahanii vs. G. candidum, R. glutinis vs. R. mucilaginosa and Trichosporon sp. [18], and to also detect complex species, like in the case of C. orthopsilosis.
5. Conclusions
The relationship between humans and animals is increasingly closer and, with it, the transfer of potentially pathogenic microorganisms between them. For that reason, medical mycology procedures must be unified between human and animal diagnoses, and databases must be available for global consultation and enlarged with isolates obtained from animals and the environment to improve the detection of emerging pathogens coming from those sources. Finaly, multidisciplinary works involving government, academia and health practitioners are necessary to detect threats to public health and generate useful information for One Health purposes.
Author Contributions
Conceptualization, A.C.-H. and N.C.-B.; methodology, A.C.-H. and N.C.-B.; validation, A.C.-H., N.C.-B. and M.C.-D.; formal analysis, A.C.-H. and N.C.-B.; investigation, A.C.-H. and N.C.-B.; resources, A.C.-H. and M.C.-D.; data curation, A.C.-H. and N.C.-B.; writing—original draft preparation, A.C.-H. and N.C.-B.; writing—review and editing, A.C.-H., N.C.-B. and M.C.-D.; visualization, A.C.-H. and N.C.-B.; supervision, A.C.-H. and M.C.-D.; project administration, A.C.-H.; funding acquisition, A.C.-H. All authors have read and agreed to the published version of the manuscript.
Funding
This research was funded by the Paid External Linkage Project 054559-0000 Diagnosis of Veterinary Mycoses from the School of Veterinary Medicine, Universidad Nacional, Costa Rica. The funds to publish this article in open access format were from the Fund to Support the Dissemination of Knowledge generated at the Universidad Nacional, Costa Rica 2024. The Vitek® 2 Systems equipment used in this research was bought with funds from the Scientific, Technological and Specialized Equipment Fund (FECTE 2015) from the Consejo Nacional de Rectores (CONARE). The equipment of MALDI-TOF was a donation from the Junta de Protección Social de San José to INCIENSA. The present study was the research project of the internship of NCB to archive their Master of Science degree in Tropical Diseases tutored by ACH in the Mycology Laboratory, School of Veterinary Medicine, Universidad Nacional, Costa Rica.
Institutional Review Board Statement
This study did not require ethical approval, since the samples were received for diagnosis.
Informed Consent Statement
Not applicable.
Data Availability Statement
All the data were included in this manuscript.
Acknowledgments
We thank Randall Rubí Chacón, Fiorella Fernández Araya, Siam Chiquillo Vergara, José Andrés Vargas Mejía, Mayte Fernández Fallas and the students of the 2023 generation of the rotating internship of veterinary medicine who collaborated in maintaining the collection of yeasts and helped with the laboratory procedures and to Diagnóstico Albéitar S.A., specially to Natalia Guzmán and Silvia Acevedo for referring isolates for identification.
Conflicts of Interest
The authors declare no conflicts of interest.
Appendix A
Descriptions of the Isolates on Sabouraud Dextrose Agar, Brilliance® Candida Agar and Gram Staining
Geotrichum candidum in SDA had a yeast-like appearance but with abundant submerged hyphae at the edges of the colony (Figure 1A). Slightly cottony colonies of a light purple color were observed in the BCA (Figure 2A). Microscopically, septate hyphae and arthroconidia with rounded ends of different lengths were observed (Figure 3A).
Cryptococcus neoformans in SDA with cream-colored, slightly raised, mucoid-appearing colonies that darken over time were observed (Figure 1B). Beige colonies were observed in the BCA (Figure 2B). Microscopically, round cells with dark walls and no hyphae were observed (Figure 3B).
Rhodotorula mucilaginosa in SDA presented bright, elevated colonies of fuchsia color (Figure 1C). Orange colonies were obtained in the BCA (Figure 2C). Microscopically, slightly oval rounded cells were observed (Figure 3C).
Prototheca zopffi in SDA presented a yeast-like appearance of cream color (Figure 1D). In the BCA, it resulted in light purple colonies (Figure 2D). Microscopically, there were sporangia of various sizes without budding or filamentation (Figure 3D).
Trichosporon asahii in SDA had cerebriform, velvety and cream-colored colonies (Figure 1E). In the BCA, we found greenish-blue, velvety, cerebriform colonies (Figure 2E). Microscopically, hyphae, arthroconidia and blastoconidia were observed (Figure 3E).
Candida parapsilosis in SDA was creamy white in appearance (Figure 1F), its color in the BCA was beige (Figure 2F) and, microscopically, its cells were ovoid in shape (Figure 3F).
Nakaseomyces glabrata is a small white- to cream-colored yeast in SDA (Figure 1G), and in BCA, it grows as cream-colored colonies (Figure 2G). Microscopically, its cells are oval, and pseudohyphae do not form (Figure 3G).
Candida tropicalis presents creamy and rough colonies towards its edges in SDA (Figure 1H). In BCA, it presents blue colonies (Figure 2H), and at the microscopic level, it presents cells from round to oval (Figure 3H).
Candida albicans in SDA had a pastry appearance and cream color (Figure 1I). In BCA, it had green colonies (Figure 2I). Its cells were round to oval, and hyphae and pseudohyphae were observed (Figure 3I).
Meyerozyma guillermondii in SDA presents flattened, cream-colored and shiny colonies (Figure 1J). In BCA, its colonies develop a purple color (Figure 2J). Microscopically, its cells range from ovoid to elongated (Figure 3J).
Malassezia pachydermatis in SDA presents circumscribed, elevated, opaque cream-colored colonies that can turn beige over time (Figure 1K). Intense brown colonies are observed in BCA (Figure 2K). Its cells are round to oval single buddings with a wide implantation base (Figure 3K).
Papiliotrema laurentii in SDA were slightly raised, cream and matte in appearance (Figure 1L); in BCA, its colonies were purple, flat and shiny (Figure 2L). At the microscopic level, very round cells of different sizes were observed (Figure 3L).
Cutaneotrichosporon jirovecii in SDA had cerebriform, shiny and mucous colonies (Figure 1M). In BCA, its growth was greenish blue (Figure 2M). Microscopically, septate hyphae with elongated arthroconidia were observed (Figure 3M).
References
- Friedman, D.Z.P.; Schwartz, I.S. Emerging Fungal Infections: New Patients, New Patterns, and New Pathogens. J. Fungi 2019, 5, 67. [Google Scholar] [CrossRef]
- World Health Organization. WHO Fungal Priority Pathogens List to Guide Research, Development and Public Health Action; World Health Organization: Geneva, Switzerland, 2022; 33p. [Google Scholar]
- Caetano, C.F.; Gaspar, C.; Martinez-de-Oliveira, J.; Palmeira-de-Oliveira, A.; Rolo, J. The Role of Yeasts in Human Health: A Review. Life 2023, 13, 924. [Google Scholar] [CrossRef]
- Morio, F. Dear medical mycologists, it is time to look outside the box. FEMS Yeast Res. 2020, 20, foz080. [Google Scholar] [CrossRef]
- Cabañes, F.J. Yeast Pathogens of Domestic Animals. In Pathogenic Yeasts, The Yeast Handbook; Ashbee, H.R., Bignell, E.M., Eds.; Springer: Berlin/Heidelberg, Germany, 2010; pp. 253–279. [Google Scholar] [CrossRef]
- Castelo-Branco, D.S.C.M.; Brilhante, R.S.N.; Paiva, M.A.N.; Teixeira, C.E.C.; Caetano, E.P.; Ribeiro, J.F.; Cordeiro, R.A.; Sidrim, J.J.C.; Monteiro, A.J.; Rocha, M.F.G. Azole-resistant Candida albicans from a wild Brazilian porcupine (Coendou prehensilis): A sign of an environmental imbalance? Med. Mycol. 2013, 51, 555–560. [Google Scholar] [CrossRef] [PubMed]
- Cabañes, F.J. Malassezia yeasts: How many species infect humans and animals? PloS Pathog. 2014, 10, e1003892. [Google Scholar] [CrossRef] [PubMed]
- Seyedmousavi, S.; Bosco, S.M.G.; de Hoog, S.; Ebel, F.; Elad, D.; Gomes, R.R.; Jacobsen, I.D.; Jensen, H.E.; Martel, A.; Mignon, B.; et al. Fungal infections in animals: A patchwork of different situations. Med. Mycol. 2018, 56, 165–187, Erratum in Med. Mycol. 2018, 56, e4. [Google Scholar] [CrossRef] [PubMed]
- Losnak, D.O.; Rocha, F.R.; Almeida, B.S.; Batista, K.Z.S.; Althoff, S.L.; Haupt, J.; Ruiz, L.S.; Anversa, L.; Lucheis, S.B.; Paiz, L.M.; et al. Molecular detection of fungi of public health importance in wild animals from Southern Brazil. Mycoses 2018, 61, 455–463. [Google Scholar] [CrossRef] [PubMed]
- Esquivel, B.D.; Rouse Salcido, E.M.; Schweiker, A.M.; Holder, B.L.; KuKanich, B.; KuKanich, K.S.; White, T.C. Fungal diversity and drug susceptibility of the oral mycobiome of domestic dogs. Front. Vet. Sci. 2023, 10, 1281712. [Google Scholar] [CrossRef] [PubMed]
- Barton, R. Laboratory Diagnosis of Yeast Infections. In Pathogenic Yeasts, The Yeast Handbook; Ashbee, H.R., Bignell, E.M., Eds.; Springer: Berlin/Heidelberg, Germany, 2010; pp. 280–309. [Google Scholar]
- Ghelardi, E.; Pichierri, G.; Castagna, B.; Barnini, S.; Tavanti, A.; Campa, M. Efficacy of Chromogenic Candida Agar for isolation and presumptive identification of pathogenic yeasts. Clin. Microbiol. Infect. 2008, 14, 141–147. [Google Scholar] [CrossRef] [PubMed]
- Alfonso, C.; López, M.; Arechavala, A.; del Perrone, M.C.; Guelfand, L.; Bianchi, M. Identificación presuntiva de Candida spp. y de otras levaduras de importancia clínica: Utilidad de Brilliance Candida Agar. Rev. Iberoam. Micol. 2010, 27, 90–93. [Google Scholar] [PubMed]
- Scharmann, U.; Kirchhoff, L.; le Saout Chapot, V.; Dziobaka, J.; Verhasselt, H.L.; Stauf, R.; Buer, J.; Steinmann, J.; Rath, P.M. Comparison of four commercially available chromogenic media to identify Candida albicans and other medically relevant Candida species. Mycoses 2020, 63, 823–831. [Google Scholar] [CrossRef]
- Taverna, C.G.; Vivot, M.E.; Arias, B.; Canteros, C.E. Manual de Interpretación de Resultados Para la Identificación de Levaduras de Interés Médico por MALDI-TOF (MALDI Biotyper-Bruker Daltonics); ANLIS Dr. C.G. Malbrán: Ciudad Autónoma de Buenos Aires, Argentina, 2021; pp. 10–46. [Google Scholar]
- Buchan, B.W.; Ledeboer, N.A. Advances in identification of clinical yeast isolates by use of matrix-assisted laser desorption ionization-time of flight mass spectrometry. J. Clin. Microbiol. 2013, 51, 1359–1366. [Google Scholar] [CrossRef]
- Walsh, T.; Hayden, R.; Larone, D.H. Larone’s Medically Important Fungi: A Guide to Identification, 6th ed.; ASM Press: Washington, DC, USA, 2018; 523p. [Google Scholar]
- de Hoog, G.S.; Guarro, J.; Gené, J.; Figueras, M.J. Atlas of Clinical Fungi: The Ultimate Benchtool for Diagnostics, 2nd ed.; Ceentralbureau voor Schimmelcultures: Utrecht, The Netherlands; Universitat Rovira i Virgili: Reus, Spain, 2000; 1126p. [Google Scholar]
- Mathews, M.S.; Ashbee, R.H. Emerging Systemic Yeast Pathogens. In Pathogenic Yeasts, The Yeast Handbook; Ashbee, H.R., Bignell, E.M., Eds.; Springer: Berlin/Heidelberg, Germany, 2010; pp. 231–251. [Google Scholar]
- Cob-Delgado, M. (Instituto Costarricense de Investigación y Enseñanza en Nutrición y Salud, Tres Ríos, Cartago, Costa Rica). Reporte de Hemocultivos Positivos por Candida spp. en Hospitales Nacionales para la Estrategia para la Vigilancia de Laboratorio de la Resistencia a los Antimicrobianos (EVILABRA) de Microorganismos de Importancia en Salud Pública 2018–2021, 2022. (Private communication).
- Caballero, E.; Boza, R.; González, K. Candidiasis sistémica. Experiencia en el Hospital San Juan de Dios 1996–1998. Rev. Costarric. Cienc. Méd 1999, 20, 153–165. [Google Scholar]
- Mora, N.; Carrillo, P. Candidemia en el Hospital San Juan de Dios: Casos del 2003 al 2005. Rev. Col. Microbiól. Químicos Clínicos Costa Rica 2005, 11, 17–19. [Google Scholar]
- Villalobos-Vindas, J.M.; Castro-Cordero, J.A.; Avilés-Montoya, A.; Peláez-Gil, M.C.; Somogyi-Pérez, T.; Sandoval-Carpio, L. Candidemia and it’s epidemiology at Hospital México. Acta Méd. Costarric. 2016, 58, 15–20. [Google Scholar]
- Ávila-Sánchez, D.; Villalobos-Zúñiga, M.A. Perfil epidemiológico y respuesta terapéutica de la infección por Cryptococcus sp. en pacientes de Costa Rica en el Hospital San Juan de Dios, período 2008–2012. Rev. Clínica Esc. Med. UCR—HSJD 2016, 1, 8–30. [Google Scholar]
- Indranil, S. Veterinary Mycology; Springer: New Delhi, India, 2015; 179p. [Google Scholar]
- Singh, K.; Ilkit, M.; Shokohi, T.; Tolooe, A.; Malik, R.; Seyedmousavi, S. Cryptococcosis: Emergence of Cryptococcus gatii in Animals and Zoonotic Potential. In Emerging and Epizootic Fungal Infections in Animals; Seyedmousavi, S., de Hoog, G.S., Guillot, J., Verweij, P.E., Eds.; Springer International Publishing: Cham, Switzerland, 2018; pp. 249–288. [Google Scholar]
- Pennisi, M.G.; Hartmann, K.; Lloret, A.; Ferrer, L.; Addie, D.; Belák, S.; Boucraut-Baralon, C.; Egberink, H.; Frymus, T.; Gruffydd-Jones, T.; et al. Cryptococcosis in cats: ABCD guidelines on prevention and management. J. Feline Med. Surg. 2013, 15, 611–618. [Google Scholar] [CrossRef]
- Stefanetti, V.; Marenzoni, M.L.; Lepri, E.; Coletti, M.; Casagrande-Proietti, S.; Agnetti, F.; Crotti, S.; Pitzurra, L.; Del Sero, A.; Passamonti, F. A case of Candida guilliermondii abortion in an Arab mare. Med. Mycol. Case Rep. 2014, 4, 19–22. [Google Scholar] [CrossRef] [PubMed]
- Brilhante, R.S.N.; de Alencar, L.P.; de Aguiar, R.; Castelo-Branco, D.S.C.; Cordeiro Texeira, C.E.; Macedo, R.B.; Texeira Lima, D.; Neto Paiva, M.A.; Jalles Monteiro, A.; Dutra Alves, N.; et al. Detection of Candida species resistant to azoles in the microbiota of rheas (Rhea americana): Possible implications for human and animal health. J. Med. Microbiol. 2013, 62, 889–895. [Google Scholar] [CrossRef] [PubMed]
- Brilhante, R.S.N.; Vago Bittencourt, P.; Castelo Branco, D.S.C.; de Oliveira, J.S.; Alencar, L.P.; de Aguiar-Cordeiro, R.; Pinheiro, M.; Nogueira-Filho, E.F.; Pereira-Neto, W.A.; Costa-Sidrim, J.J.; et al. Trends in antifungal susceptibility and virulence of Candida spp. from the nasolacrimal duct of horses. Med. Mycol. 2016, 54, 147–154. [Google Scholar] [CrossRef] [PubMed]
- Scott, C.J. A review of fungal endometritis in a mare. Equine Vet. Educ. 2020, 32, 444–448. [Google Scholar] [CrossRef]
- Beltaire, K.A.; Cheong, S.H.; Coutinho da Silva, M.A. Retrospective study on equine uterine fungal isolates and antifungal susceptibility patterns (1999–2011). Equine Vet. J. 2012, 44, 84–87. [Google Scholar] [CrossRef]
- Azarvandi, A.; Khosravi, A.R.; Shokri, H.; Talebkhan Garoussi, M.; Gharahgouzlou, F.; Vahedi, G.; Sharifzadeh, A. Presence and distribution of yeasts in the reproductive tract in healthy female horses. Equine Vet. J. 2017, 49, 614–617. [Google Scholar] [CrossRef] [PubMed]
- Scott, D.W.; Miller, W.H. Equine Dermatology, 2nd ed.; Elsevier Saunders: Maryland Hights, MI, USA, 2011; Chapter 5; p. 205. [Google Scholar]
- Macruz, R.; dos Santos, M.R.; Porto, E. Geotricose em equino Puro Sangue Ingles. Rev. Facult. Med. Ved. Zootec. U Sao Paulo 1978, 15, 93–98. [Google Scholar]
- Campos González, N.B.; Calderón-Hernández, A.; Valverde-Altamirano, E.; Alfaro-Alarcón, A. Canine Protothecosis in Costa Rica; What to Look for and When to Suspect? Rev. Cienc. Vet. 2022, 40, 1–17. [Google Scholar] [CrossRef]
- Becker, P.; Normand, A.C.; Vanantwerpen, G.; Vanrobaeys, M.; Haesendonck, R.; Vercammen, F.; Stubbe, D.; Piarroux, R.; Hendrickx, M. Identification of fungal isolates by MALDI-TOF mass spectrometry in veterinary practice: Validation of a web application. J. Vet. Diagn. Invest. 2019, 31, 471–474. [Google Scholar] [CrossRef] [PubMed]
- Dünner, C.; Pastor, G. Manual de Manejo, Medicina y Rehabilitación de Perezosos; Fundación Huálamo: Valdivia, Chile, 2017; pp. 102–135. [Google Scholar]
- Moore, T.A.; Lamberski, N. Retrospective study of the morbidity and mortality in the two-toed sloth (Choleopus hoffmanni and Choloepus didactylus) in North America. In Proceedings of the American Association of Zoo Veterinarians, Orlando, FL, USA, 18–23 September 2001. [Google Scholar]
- Kaiser, C.; Berners-Schultheis, C.; Schuster, R.K.; Kinne, J. Gastric candidiasis in a two-toed sloth (Choloepus didactylus) in the United Arab Emirates (UAE). In Proceedings of the International Conference on Diseases of Zoo and Wild Animals, Vienna, Austria, 8–11 May 2013. [Google Scholar]
- Berrocal, A. Mycotic gastritis probably due to Candida sp in a two-toed sloth (Choloepus hoffmanni). In Proceedings of the 24th Annual Zoo and Wildlife Pathology with Focus on Fungal Diseases, Frisco, TX, USA, 23–29 September 2017. [Google Scholar]
- Cavalieri, D.; Valentini, B.; Stefanini, I. Going wild: Ecology and genomics are crucial to understand yeast evolution. Curr. Opin. Genet. Dev. 2022, 75, 101922. [Google Scholar] [CrossRef]
- Mancianti, F.; Nardoni, S.; Ceccherelli, R. Occurrence of yeasts in psittacines droppings from captive birds in Italy. Mycopathologia 2002, 153, 121–124. [Google Scholar] [CrossRef]
- Weinstein, S.B.; Stephens, W.Z.; Greenhalgh, R.; Round, J.L.; Dearing, M.D. Wild herbivorous mammals (genus Neotoma) host a diverse but transient assemblage of fungi. Symbiosis 2022, 87, 45–58. [Google Scholar] [CrossRef]
- Normand, A.C.; Gabriel, F.; Riat, A.; Cassagne, C.; Bourgeois, N.; Huguenin, A.; Chauvin, P.; De Geyter, D.; Bexkens, M.; Rubio, E.; et al. Optimization of MALDI-ToF mass spectrometry for yeast identification: A multicenter study. Med. Mycol. 2020, 58, 639–649. [Google Scholar] [CrossRef] [PubMed]
- Pavlovic, M.; Mewes, A.; Maggipinto, M.; Schmidt, W.; Messelhäußer, U.; Balsliemke, J.; Hörmansdorfer, S.; Busch, U.; Huber, I. MALDI-TOF MS based identification of food-borne yeast isolates. J. Microbiol. Methods 2014, 106, 123–128. [Google Scholar] [CrossRef] [PubMed]
- Nualmalang, R.; Thanomsridetchai, N.; Teethaisong, Y.; Sukphopetch, P.; Tangwattanachuleeporn, M. Identification of Pathogenic and Opportunistic Yeasts in Pigeon Excreta by MALDI-TOF Mass Spectrometry and Their Prevalence in Chon Buri Province, Thailand. Int. J. Environ. Res. Public Health 2023, 20, 3191. [Google Scholar] [CrossRef] [PubMed]
Disclaimer/Publisher’s Note: The statements, opinions and data contained in all publications are solely those of the individual author(s) and contributor(s) and not of MDPI and/or the editor(s). MDPI and/or the editor(s) disclaim responsibility for any injury to people or property resulting from any ideas, methods, instructions or products referred to in the content. |
© 2024 by the authors. Licensee MDPI, Basel, Switzerland. This article is an open access article distributed under the terms and conditions of the Creative Commons Attribution (CC BY) license (https://creativecommons.org/licenses/by/4.0/).